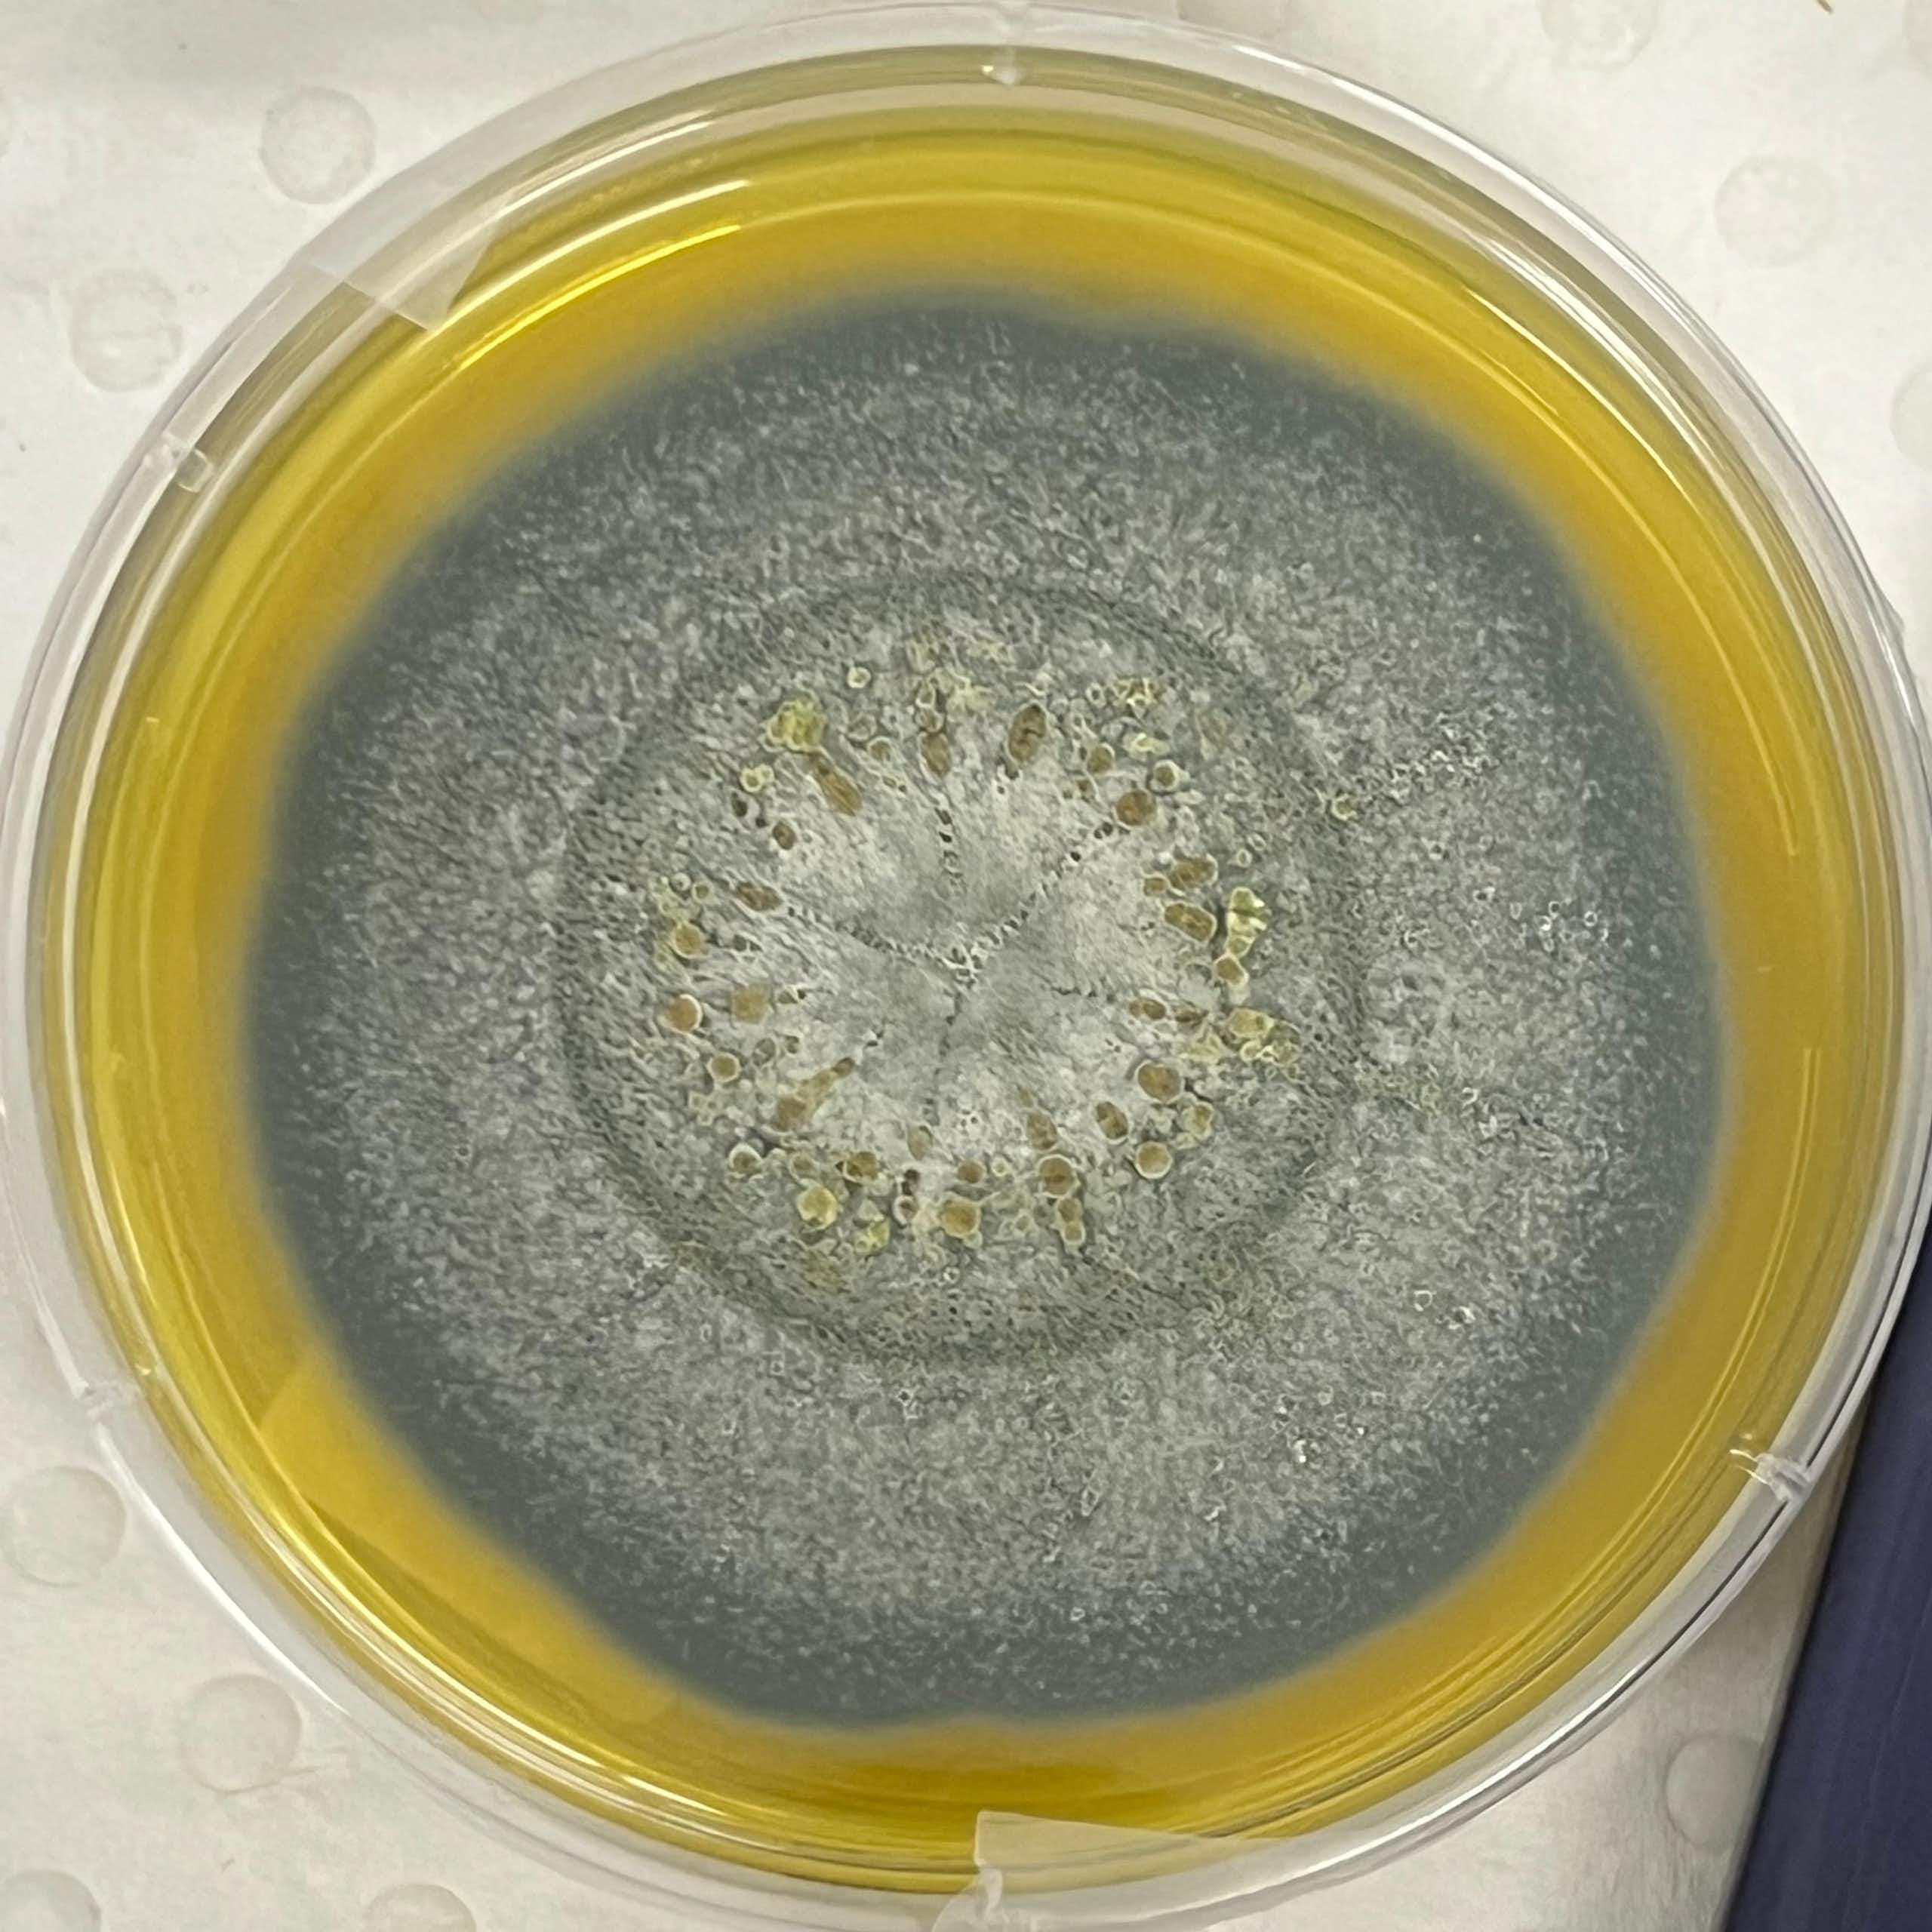
Close-up of a petri dish with a kind of mould

US-Israel attacks on Iran

Top Stories
Royals in crisis
More top stories
Start your day with evidence-based news.
Get our free daily newsletterNew research
Federal politics
World
Climate
Sport
Podcasts
Reviews
Your say
Are you an academic expert who wants to share your knowledge?
Pitch an articleMost read this week
- 1.
NASA wants to send humans to Mars in the 2030s − a crewed mission could unlock some of the red planet’s geologic mysteries
Joel S. Levine, William & Mary

- 2.
Bob Brown is right – it’s time environmentalists talked about the population problem
Colin D. Butler, Australian National University

- 3.
What our teeth reveal about the growing gap between rich and poor
Eve Vincent, Macquarie University

- 4.
How the royal family brand can weather Andrew Mountbatten-Windsor’s arrest
Pauline Maclaran, Royal Holloway, University of London

- 5.
Michael Caine’s voice is iconic. Why would he sell that to AI?
Amy Hume, The University of Melbourne